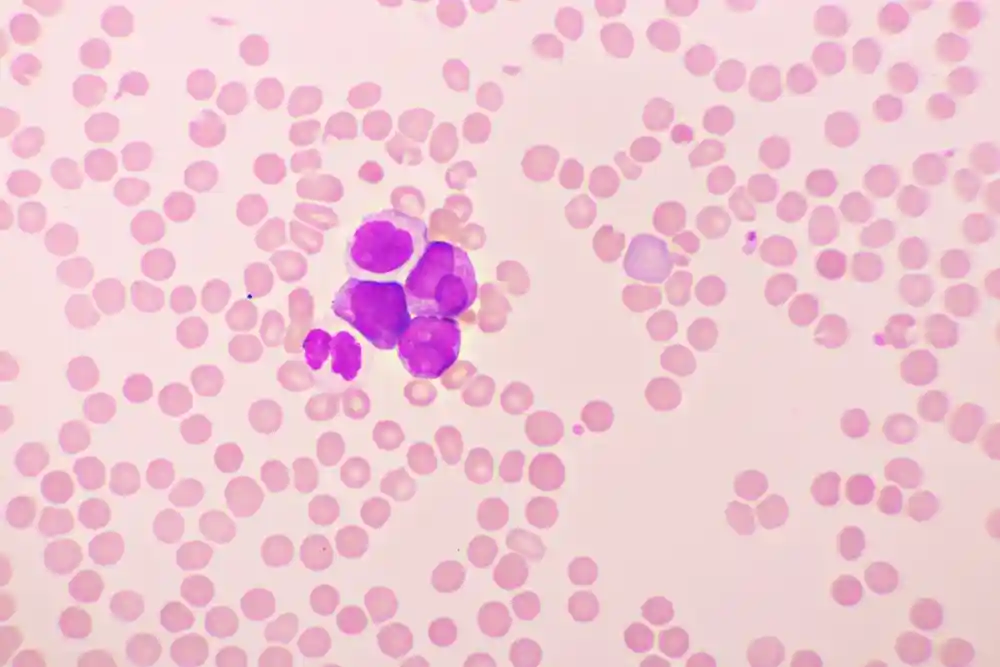

Acute Promyelocytic Leukemia
It is a subtype of acute myeloid leukemia that deserves special consideration because it is the most aggressive and life-threatening. In this type of leukemia, there are excessive promyelocytes in the bone marrow. These cells are precursors of white blood cells, and they take up extra space in the bone marrow, not allowing for the appropriate formation of other cell lines, including red blood cells and platelets.
Acute promyelocytic leukemia is more common in older adults and middle-aged adults, but people of all ages can have this type of leukemia. The diagnosis is made by performing a series of tests and detecting a few proteins and chromosomal aberrations in bone marrow samples.